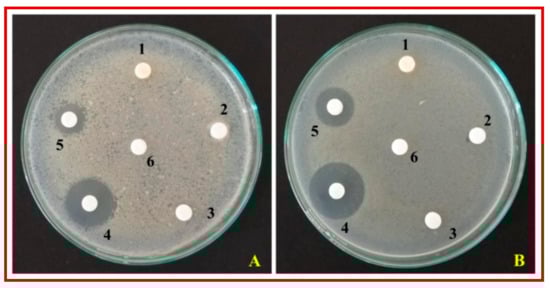

Abstract
Cinnamomum verum plant extract mediated propellant chemistry route was used for the green synthesis of zinc oxide nanoparticles. Prepared samples were confirmed for their nano regime using advanced characterization techniques such as powder X-ray diffraction and microscopic techniques such as scanning electron microscopy and transmission electron microscopy. The energy band gap of the green synthesized zinc oxide (ZnO)-nanoparticles (NPs) were found between 3.25–3.28 eV. Fourier transmission infrared spectroscopy shows the presence of Zn-O bond within the wave number of 500 cm−1. SEM images show the specific agglomeration of particles which was also confirmed by TEM studies. The green synthesized ZnO-NPs inhibited the growth of Escherichia coli and Staphylococcus aureus with a minimum inhibitory concentration (MIC) of 125 µg mL−1 and 62.5 µg mL−1, respectively. The results indicate the prepared ZnO-NPs can be used as a potential antimicrobial agent against harmful pathogens.
1. Introduction
Most of the antibacterial compounds are of bulk complex materials having high toxicological side effects [1,2,3,4,5]. Recent studies on antibacterial activity using nanoparticles (NPs) have shown to reduce the side effects, although the data are both limited and controversial [6,7,8,9]. The antibacterial activity of NPs is attributed to their nano scale dimensions, changed electronic/optical transitions and high surface to volume ratio which leads to improved surface chemistry and quantum confinement effects [10,11]. Nano research has created various possibilities in surface-modified applications [12,13,14]. Among the metal oxide nanoparticles, zinc oxide (ZnO) NPs are one of the most extensively studied nanoparticles due to its wide band gap energy (~3.37 eV) making them applicable in the field of photonics and nanoelectronics fields including semiconductor production. These ZnO nanoparticles also act as an agent to block UV radiation making them useful in the field of by dermatitis for the prevention of skin diseases [15,16]. ZnO nanoparticles can be obtained through various methods, viz., thermal evaporation, magnetic sputtering, solution combustion, molecular beam epitaxial, pulsed laser deposition, etc. [17,18,19,20]. Nowadays it has been proved that the green synthesis of NPs is eco-friendly, low cost and is less toxic when compared to other conventional synthesis methods [21,22]. Apart from the above-mentioned properties, these ZnO-NPs synthesized through plant extracts are also known to possess efficient antibacterial properties [1,3,10,21].
Cinnamomum verum J. Presl is an evergreen tree belonging to the family Lauraceae, abundantly found in Sri Lanka and other parts of Asian countries [23,24]. The different parts of the plant are used in Indian traditional medicine for the treatment of antibacterial, antifungal and anti-inflammatory, etc. [25,26,27,28].The cinnamon bark extract is one of the major bioactive compounds which have been reported to possess many biological activities such as antibacterial, antibiofilm, anthelmintic, anticancer and antifungal activity [29,30,31,32,33].Due to its vast biological potentialities, in the present study, C. verum bark extract was used for the green synthesis of ZnO NPs. Structural, morphological and optical studies were investigated by the advanced characterization techniques. Antibacterial activity was studied by the disc diffusion and broth microdilution method and supported the observations by the fluorescence microscopic method.
2. Materials and Synthesis Method
2.1. Collection of Plant Material and Green Synthesis of ZnO-NPs
Cinnamomum verum plant was collected from Gandhi Krishi Vigyan Kendra (GKVK), University of Agricultural Sciences, Bangalore, India (12°35′ N latitude and 77°35′ E longitude and at an elevation of 930 m above mean sea level) based on an ethno botanical survey. The collected plant material was authenticated by a Prof. M.S. Sudarshana, Taxonomist, Department of Studies in Botany, University of Mysore. C. verum bark material (50 g) was rinsed in de-ionized water (100 mL), dried at 35–40 °C for 48 h using an oven and further powdered by a sterile electric blender. The powdered C. verum bark was extracted with hexane (1:5, w/v) and the resultant extract was filtered through sterile Whatman No. 1 filter paper. The obtained filtrate was used for the green synthesis of ZnO-NPs. To predict the major compounds of C. verum bark extract, gas chromatography-mass spectrophotometer (GC-MS) analyzed was carried out using Shimadzu GC-MSQP2010 (Tokyo, Japan) equipped with a mass selective detector. Green synthesis of ZnO-NPs was carried out by the addition of zinc nitrate hexahydrate (2 g) to C. verum hexane extract at different concentrations (5, 10, 15, 20 and 25 mL) and kept on a magnetic stirrer (45–60 °C) until the solution becomes a paste. The resultant mixture was transferred to a silica crucible (individually) and kept in a muffle furnace for 2 h at 400 ± 10 °C. The resultant, ZnO nanoparticles were named ZnO(a), ZnO(b), ZnO(c), ZnO(d) and ZnO(e), respectively for the ratio of C. verum to ZnO-NPs.
2.2. Characterization of ZnO NPs
UV-Vis spectral analysis of a sonicated sample of ZnO-NPs (1 mg mL−1 in de-ionized water) was performed using the Systronic model (Double beam spectrometer 2203) at room temperature in the range of 200 to 800 nm. The green synthesized ZnO-NPs were characterized by powder X-ray Diffractometer (PXRD, Philips PW 3050/10 model, Cukα (1.541Ǻ) radiation. The data were collected over a 2θ range from 25° to 80° with a scanning rate of 0.02° with a counting time of 1 s per step. The topographic features of each ZnO NPs were visualized with an SEM (Carl Zeiss, Jena, Germany) in high vacuum mode at 15 kV. To determine the size of the ZnO NPs transmission electron microscopy (TEM) examination was performed on Philips model CM 200 instrument. The characteristic functional groups present in the ZnO NPs were carried out in FT-IR spectroscopy (Perkin Elmer Spectrum 1000) in attenuated total reflection mode (spectral range of 400 to 4000 cm−1) [34].
2.3. Antibacterial Activity
The bacterial strains of Staphylococcus aureus (MTCC 7443) (gram-positive) and Escherichia coli (MTCC 7410) (gram-negative) cultures were procured from Microbial Type Culture Collection (IMTECH, Chandigarh, India) and sub-cultured and maintained on Muller Hinton medium. The stock solution of ZnO-NPs (80 mg mL−1) was subjected to sonication (15 min) before subjecting to antibacterial studies.
2.3.1. Disc Diffusion Method
The disc diffusion method was used to test the antibacterial efficacy of green synthesized ZnO-NPs against the test bacterial pathogens [35]. About 100 µL (1.5 × 108 CFU mL−1) of the active culture of each of the bacterium (grown on Muller Hinton broth medium for 12 h at 37 °C) was spread uniformly on Muller Hinton medium in Petri plates by a sterile glass spreader. The dry 6 mm sterile discs impregnated with ZnO-NPs (25 µL) (2 mg disc−1) was placed on Muller Hinton plates uniformly seeded with the test bacterial inoculum. The sterile discs impregnated with 25 µL streptomycin (25 µg disc−1) and sterile distilled water (SDW) served as a positive and negative control, respectively. The inoculated Petri plates were kept in an incubator for 24 h (at 37 °C) and the inhibition zone formed around the discs was measured and tabulated.
2.3.2. Minimum Inhibitory Concentration (MIC)
The MIC of green synthesized ZnO-NPs was also determined by following the broth micro dilution technique [36]. The green synthesized ZnO-NPs (2 mg mL−1) in SDW served as a stock solution. About 100 μL of Muller Hinton broth medium was added into each well of the 96-well ELISA plate followed by an equal volume of ZnO-NPs stock solution and 2-fold serially diluted (2 to 0.003 mg mL−1). To each well, 10 μL of test bacterial (1.5 × 108 CFU mL−1) suspension was added and the plates were incubated in an incubator for 24 h (at 37 °C). The incubated ELISA plates were measured for absorbance (at 620 nm) using ELISA plate reader (LabTech 4000). The MIC was also confirmed by adding (10 μL well-1) 2,3,5- triphenyl tetrazolium chloride (TTC) (2 mg mL−1) and incubating for 30 min under dark conditions. The change in color observed in the wells was considered as the MIC.
2.3.3. Morphological Evaluation of Bacterial Cells by Fluorescence Microscopy
Fluorescence microscopy was used to distinguish the live and dead cells upon treatment with ZnO-NPs with minor modifications [37]. To 100 µL bacterial cell suspensions (1.5 × 108 CFU mL−1), 50 µL of ZnO-NPs (2 mg) were added and mixed thoroughly and kept for incubation at 37 ± 2 °C for 24 h, while the untreated cells served as control. After incubation, the mixture was centrifuged (at 5000 rpm for 5 min at 4 °C) and the pellet was washed thrice with phosphate buffer saline (PBS). Each of the samples obtained was mixed with fluorescent dye solution of ethidium bromide (EB) and acridine orange (AO) at 1:1 ratio (AO/EB 100 μg mL−1) and incubated for 30 min. After incubation, the mixture was centrifuged and again rinsed with PBS, about 5 µL bacterial cell suspension was placed on sterilized grease free slide and covered by glass cover slip and viewed at 40× in Carl Zeiss fluorescence microscope (Lawrence and Mayo, Germany) with excitation filter 430 to 470 nm.
2.4. Statically Analysis
The antibacterial studies were carried out with four replicates for each experiment and were statistically analyzed by subjecting to arcsine transformation and analysis of variance (ANOVA) using SPSS, version 17 (SPSS Inc., Chicago, IL, USA). The significant differences between the treatments mean values were determined by honestly significant difference (HSD) obtained by Tukey’s test at p ≤ 0.05 levels.
3. Results and Discussion
3.1. Collection of Plant Material and Green Synthesis of ZnO-NPs
The gas chromatography mass spectrometer (GC-MS) analytical method was used to detect the secondary metabolites present in the bark extract of C. verum. From the results of GC-MS analysis, eugenol was detected as one of the major components in the extract (Figures S1 and S2) which is reported to possess many biological activities [30,31,32,33]. It may be noted that, to date, the exact mechanism involved during the formation of nanoparticles from plant extract is not reported. Hence, in the present study, we have provided aplausible mechanism involved during the formation of ZnO-NPs by capping of eugenol present in the plant extract (Figure 1). It is noted from previous studies that zinc ions (Zn2+) will cap with available secondary metabolites of plant extract to form ZnO-NPs [38,39].

Figure 1.
The plausible mechanism involved during the formation of zinc oxide (ZnO)-nanoparticles (NPs) from the bark extract of C. verum.
3.2. Characterization of ZnO NPs
The UV-Visible absorption spectra showed a distinct absorption peak around at ~370 to 375 nm (Figure 2 and Figure S3) with band gap energy between 3.25 to 3.28 eV (Table 1). It has been previously reported that the ZnO-NPs possess a distinct absorption spectrum between 280 to 400 nm, and due to this characteristic feature, these nanoparticles have been employed in pharmaceutical and biological applications [40,41].The PXRD profiles for the ZnO prepared with different concentrations of C. verum hexane extract are presented in Figure 3A. Rietveld structural refinement was performed by using the Full-prof program to analyze the crystalline structure and unit cell of the fabricated ZnO-NPs. The obtained Rietveld refinement and microstress results of the synthesized particles are summarized in Table 1 and the fitment profile for C. verum ZnO (c) is depicted in Figure 3B.The PXRD profile showed the diffraction peaks which are in alignment to the hexagonal Wurtzite phase of zinc oxide (JCPDS card No. 89–1397) which includes Miller indices (100), (002), (101), (102), (110), (103), (200), (112), (201), (004) and (202) for various concentration (ZnO(a), ZnO(b), ZnO(c), ZnO(d) and ZnO(e)). In addition, all the diffraction peaks were well assigned to the hexagonal wurtzite phase of ZnO (JCPDS card No. 36–1451). The presence of the sharp high intensity peaks indicates high crystallinity of the nanoparticles. The crystallite size and strain present in the ZnO were estimated by using both Debye–Scherrer’s (DS) formula and W–H approach and are listed in Table 1. Statistical validity provided with Rietveld refinement showed the goodness of fit (GoF) nearer to one indicates the better fitting and without any impurities.SEM images of all the green synthesized ZnO-NPs are shown in Figure 4A–E. All the SEM images showed the agglomeration of ZnO-NPs. Transmission electron microscopy (TEM) images of ZnO-NPs showed the nano-regime as showed in Figure 5A, while Figure 5B shows the selected area electron diffraction (SAED) pattern revealing the green synthesized ZnO-NPs are of polycrystalline in nature. All the PXRD peaks (Miller indices) match with the SAED pattern of the green synthesized nanoparticles. D-spacing and the periodic arrangement of ZnO-NPs are shown in Figure 6C and the estimated d-spacing value for the sample was found to be 0.32 nm thereby confirming the clear separation of the inter-planar spacing. To confirm the phase transformation and purity of the ZnO, FT-IR spectra were recorded as showed in Figure 6. All the FT-IR spectra showed a wide band at 3311 cm−1 thereby indicating the presence of surface hydroxyl groups (Figure S4). Distinct bands observed around 496 cm−1 relates to the stretching vibrations and the bending modes of Zn–O groups.

Figure 2.
UV-visible spectra of various ZnO samples prepared using different concentrations of C. verum.

Table 1.
Lattice parameters, crystallite sizes, micro stress and energy band gap values of ZnO prepared by various C. verum concentrations.

Figure 3.
PXRD patterns of ZnO-NPs (A) and shift in the (101) plane obtained using various concentrationsof C. verum plant extract (B); Rietveld refined fitment showed for the ZnO(c) (C).

Figure 4.
SEM micrograph ofZnO-NPs obtained using various concentration of C. verumplant extract (A) ZnO(a); (B) ZnO(b); (C) ZnO(c); (D) ZnO(d); (E) ZnO(e).

Figure 5.
TEM image of ZnO(c) (A); SAED pattern of ZnO NPs (B); High-resolution transmission electron microscopy (HRTEM) with d-spacing (C).

Figure 6.
FT-IR Spectra of ZnO-NPs prepared using different concentrations of C. verum extract.
3.3. Antibacterial Activity
3.3.1. Disc Diffusion Method
The green synthesized ZnO-NPs significant inhibition against the test pathogens (S. aureus and E. coli) compared to control. ZnO-NPs offered a maximum zone of inhibition of 16.75 mm and 13.25 mm was observed against S. aureus and E. coli, respectively. From the study, it was observed that the gram-positive (S. aureus) bacterium was more sensitive to the green synthesized ZnO-NPs compared to the gram-negative (E. coli) bacterium. The obtained results are in good agreement with the findings of other researchers, wherein it was observed that gram-positive (S. aureus and Bacillus subtilis) bacteria were more sensitive to ZnO-NPs compared to gram-negative (E. colia and Pseudomonas aeruginosa) bacteria [42,43,44,45]. Further, it has been noted that Zn2+ ions will stimulate the growth of both E. coli and S. aureus but the concentration required by S. aureusis lesser (micro molar range) [46,47] compared E. coli (milli molar range) [48,49] and these differences in the metabolism-dependent processes of E. coli and S. aureus may have a direct role in the observed difference in toxicity thresholds of these organisms [49]. Further, it was also noted that the positive control (streptomycin 25 μg disc−1) offered a zone of inhibition of 24.25 and 22 mm against S. aureus and E. coli, respectively while all the test samples were unable to inhibit the growth of test pathogens (Figure 7 and Table 2).The results of the disc diffusion study showed that except for ZnO-NPs and streptomycin all other treatments were unable to inhibit the growth of S. aureus and E. coli. The results of the study are in line with the findings of Mahendra et al. [50], wherein biosynthesized ZnO-NPs offered better inhibition to test pathogens compared to plant extract. The antibacterial properties of the biosynthesized ZnO-NPs have been attributed to the disruption of the cell membrane of the pathogen possibly due to the generation of hydrogen peroxide (H2O2) as they can infiltrate into the cell membrane thereby causing severe damage to bacteria [51].
Figure 7.
Antibacterial activity of ZnO-NPs green synthesized using C. verum hexane extract. (A): E. coli; (B): S. aureus; 1: C. verum hexane extract; 2: Hexane; 3: Hexane + zinc nitrate hexahydrate; 4: Streptomycin; 5: ZnO-NPs; 6: Sterile distilled water.

Table 2.
Antibacterial activity of ZnO-NPs green synthesized using C. verum hexane extract.
3.3.2. Minimum Inhibitory Concentration (MIC)
Further, the MIC of ZnO-NPs was determined by the broth microdilution method along with control. From the results, it was noted that the green synthesized ZnO-NPs showed a MIC of 62.5 µg mL−1 and 125 µg mL−1, while the streptomycin showed and MIC of 7.8 µg mL−1 for S. aureus and E. coli, respectively (Table 2 and Figure S5). The results of the present study are in accordance with the findings of many other researchers wherein plant extract mediated synthesis of ZnO-NPs offered significant MIC activity below 0.5 mg mL−1 against both E. coli and S. aureus [50,52].
3.3.3. Morphological Evaluation of Bacterial Cells by Fluorescence Microscopy
The morphological changes that occurred during the inhibition of bacterial pathogens were carried out by selective staining for live and dead cell analysis. Among the fluorescent nucleic acid dyes used, AO is known to stain both live and dead cells, while EB can penetrate only cells with damaged cell membranes [53]. The fluorescent dye analysis confirmed that the morphology of the E. coliand S. aureuscells wasdamaged upon interaction with the green synthesized ZnO-NPswhich was confirmed by the presence of reddish-orange cells which cell membrane damage (Figure 8b,d). In addition, the appearance of green fluoresced E. coli and S. aureus cells which were treated with SDW confirmed the intact cell wall structures (Figure 8a,c). Similar to the study, Mahendra et al. [50] and Hameed et al. [54] have also used AO/EB dye to study the live and dead cells of pathogenic bacteria upon interaction with biosynthesized ZnO-NPs from plant extract. In addition, Table 3 shows the importance of the ZnO-NPs and their inhibitory effects against the harmful pathogens including E. coli and S. aureus. The table represents the method of preparation, crystallite size, morphology, etc., of ZnO-NPs and the results of the present study are also compared.

Figure 8.
Fluorescent microscopic (40×) images of (a) E. coli and (c) S. aureus untreated control bacterial cells and (b) E. coli and (d) S. aureustreated with ZnO-NPs. In both series, green dots represent live bacterial cells and yellow/orange dots represent dead cells.

Table 3.
Comparison of obtained antibacterial results of prepared samples with the literature.
4. Conclusions
In conclusion, the green synthesized ZnO-NPs from the hexane extract C. verum bark were evaluated for its antibacterial efficacy against S. aureus and E. coli.PXRD and TEM results confirm the crystallites size as ~45 nm. The energy bandgap of the compounds is in the range of 3.25–3.28 eV confirms the wide bandgap nature of the samples and the results obtained are in proper alignment with the reported literature. Rietveld refinement technique supported the hexagonal Wurtzite phase of ZnO with the goodness of fitment very close to one. There is a small shift in the major PXRD peak indicates the orientation of (101) plane due to plant extract. Minimum inhibitory concentration of ZnO(c) NPs was 62.5 µg mL−1 and 125 µg mL−1 for S. aureus and E. coli, respectively.
Supplementary Materials
The following are available online at https://www.mdpi.com/2218-273X/10/2/336/s1, Figure S1. Chromatogram of C. verum bark hexane extract analyzed on GC-MS, Figure S2. Retention time (RT) Library of C. verum bark hexane extract showing the eugenol content, Figure S3. UV- visible spectra of various ZnO-NPs green synthesized using different concentration of C. verum hexane extract, Figure S4. FT-IR Spectra of C. verum bark hexane extract (A) and its green synthesizesd ZnO-NPs (B), Figure S5. Minimum Inhibitory Concentration (MIC) of green synthesized ZnO-NPs from C. verum bark. hexane extract. A- E. coli; B- S. aureus. Row 1: ZnO-NPs; Row 2: Plant extract; Row 3: Hexane; Row 4: Hexane + Zinc nitrate hexahydrate; Row 5: Gap; Row 6: Sterile Distilled Water; Row 7: Streptomycin.
Author Contributions
Conceptualization, M.A.A. (Mohammad Azam Ansari), M.M. and T.R.L; methodology, D.P., T.R.L., S.R.N. and M.A.A. (Mohammad A. Alzohairy); software, A.A., M.A.A. (Mohammad Azam Ansari), M.A.A. (Mohammad A. Alzohairy); validation by all authors; formal analysis, S.M.M.A., M.A.A. (Mohammad Azam Ansari) and M.N.A.; investigation, T.R.L., S.B.S., H.G.G., N.K., B.S.A., A.A., and M.M.; resources, M.M., K.N.A., A.C.U., M.A.A. (Mohammad Azam Ansari), M.A.A. (Mohammad A. Alzohairy), M.N.A., and S.M.M.A.; data curation, M.M., M.A.A. (Mohammad Azam Ansari), D.P., B.S.A., and M.A.A. (Mohammad Azam Ansari) writing—original draft preparation, T.R.L., M.M., M.A.A. (Mohammad Azam Ansari), A.A., and S.R.N.; writing—review and editing, by all authors; visualization, T.R.L., M.M., S.R.N., M.A.A. (Mohammad Azam Ansari) supervision, S.R.N. and K.N.A.; project administration, S.R.N., K.N.A. and M.A.A.; funding acquisition, M.A.A. (Mohammad Azam Ansari), M.A.A. (Mohammad A. Alzohairy), K.N.A. and S.R.N. All authors have read and agreed to the published version of the manuscript.
Funding
This work was funded by Deanship of Scientific Research Project number (2019-091-IRMC), Imam Abdulrahman Bin Faisal University, Dammam, Riyadh, Saudi Arabia.
Acknowledgments
The authors LTR and MM would like to acknowledge the University Grants Commission (UGC)-New Delhi, India for providing financial support under UGC Post-Doctoral Fellowship for SC/ST Candidates (No. F/PDFSS-2015-17-KAR-11458 and No. F/PDFSS-2015-17-KAR-11846). The authors are also grateful to the Institution of Excellence (IOE); University with Potential for Excellence (UPE), Department of Studies in Botany; Department of Studies in Biotechnology, University of Mysore, Mysuru and Institute for Research and Medical Consultations (IRMC), Imam Abdulrahman Bin Faisal University, Dammam, Saudi Arabia for providing instrumentation facilities.
Conflicts of Interest
The authors declare no competing interests.
References
- Hajipour, M.J.; Fromm, K.M.; Ashkarran, A.A.; De Aberasturi, D.J.; De Larramendi, I.R.; Lu, J.; Serpooshan, V.; Parak, W.J.; Mahmoudi, M. Antibacterial properties of nanoparticles. Trends Biotechnol. 2012, 30, 499–511. [Google Scholar] [CrossRef] [PubMed]
- Maynard, A.D.; Warheit, D.B.; Philbert, M.A. The New Toxicology of Sophisticated Materials: Nanotoxicology and Beyond. Toxicol. Sci. 2011, 120. [Google Scholar] [CrossRef] [PubMed]
- Ji, J.; Zhang, W. Bacterial behaviors on polymer surfaces with organic and inorganic antimicrobial compounds. J. Biomed. Mater. Res. 2008, 88, 448–453. [Google Scholar] [CrossRef] [PubMed]
- Goharshadi, E.K.; Ding, Y.; Jorabchi, M.N.; Nancarrow, P. Ultrasound-assisted green synthesis of nanocrystalline ZnO in the ionic liquid [hmim][NTf2]. Ultrason. Sonochem. 2009, 16, 120–123. [Google Scholar] [CrossRef] [PubMed]
- Sharifalhoseini, Z.; Entezari, M.H.; Jalal, R. Direct and indirect sonication affect differently the microstructure and the activity. Ultrason. Sonochem. 2015, 27, 466–473. [Google Scholar] [CrossRef]
- Abbasalipourkabir, R.; Moradi, H.; Zarei, S.; Asadi, S.; Salehzadeh, A.; Ghafourikhosroshahi, A.; Mortazavi, M.; Ziamajidi, N. Toxicity of zinc oxide nanoparticles on adult male Wistar rats. Food Chem. Toxicol. 2015, 84, 154–160. [Google Scholar] [CrossRef]
- Hanagata, N.; Morita, H. Calcium ions rescue human lung epithelial cells from the toxicity of zinc oxide nanoparticles. J. Toxicol. Sci. 2015, 40, 625–635. [Google Scholar] [CrossRef]
- Skwarek, E. Surfactants decrease the toxicity of ZnO, TiO2 and Ni nanoparticles to Daphnia magna. Ecotoxicology 2015, 24, 1923–1932. [Google Scholar]
- Senapati, V.A.; Kumar, A.; Gupta, G.S.; Pandey, A.K.; Dhawan, A. ZnO nanoparticles induced inflammatory response and genotoxicity in human blood cells: A mechanistic approach. Food Chem. Toxicol. 2015, 85, 61–70. [Google Scholar] [CrossRef]
- Matinise, N.; Fuku, X.G.; Kaviyarasu, K.; Mayedwa, N.; Maaza, M. Applied Surface Science ZnO nanoparticles via Moringa oleifera green synthesis: Physical properties & mechanism of formation. Appl. Surf. Sci. 2017, 406, 339–347. [Google Scholar]
- Guo, B.-L.; Han, P.; Guo, L.-C.; Cao, Y.-Q.; Li, A.-D.; Kong, J.-Z.; Zhai, H.; Wu, D. The Antibacterial Activity of Ta-doped ZnO Nanoparticles. Nanoscale Res. Lett. 2015, 10, 1047. [Google Scholar] [CrossRef] [PubMed]
- Méndez-Medrano, M.G.; Kowalska, E.; Lehoux, A.; Herissan, A.; Ohtani, B.; Bahena, D.; Briois, V.; Colbeau-Justin, C.; Rodriguez-Lopez, J.; Remita, H. Surface Modification of TiO2 with Ag Nanoparticles and CuO Nanoclusters for Application in Photocatalysis. J. Phys. Chem. C 2016, 120, 5143–5154. [Google Scholar] [CrossRef]
- Day, R.; Mankin, M.N.; Lieber, C.M. Plateau–Rayleigh Crystal Growth of Nanowire Heterostructures: Strain-Modified Surface Chemistry and Morphological Control in One, Two, and Three Dimensions. Nano Lett. 2016, 16, 2830–2836. [Google Scholar] [CrossRef] [PubMed]
- Piella, J.; Bastus, N.G.; Puntes, V. Size-Controlled Synthesis of Sub-10-nanometer Citrate-Stabilized Gold Nanoparticles and Related Optical Properties. Chem. Mater. 2016, 28, 1066–1075. [Google Scholar] [CrossRef]
- Kim, E.; Kim, M.; Im, N.; Park, S.N. Photolysis of the organic UV filter, avobenzone, combined with octyl methoxycinnamate by nano-TiO2 composites. J. Photochem. Photobiol. B Boil. 2015, 149, 196–203. [Google Scholar] [CrossRef] [PubMed]
- Lee, G.-H. Morphology and luminescence properties of ZnO micro/nanostructures synthesized via thermal evaporation of Zn–Mg mixtures. Ceram. Int. 2015, 41, 8475–8480. [Google Scholar] [CrossRef]
- Inguva, S.; Gray, C.; McGlynn, E.; Mosnier, J.-P. Origin of the 3.331 eV emission in ZnO nanorods: Comparison of vapour phase transport and pulsed laser deposition grown nanorods. J. Lumin- 2016, 175, 117–121. [Google Scholar] [CrossRef]
- Chebil, W.; Boukadhaba, M.; Fouzri, A. Epitaxial growth of ZnO on quartz substrate by sol-gel spin-coating method. Superlattices Microstruct. 2016, 95, 48–55. [Google Scholar] [CrossRef]
- Sreedhar, A.; Kwon, J.H.; Yi, J.; Kim, J.S.; Gwag, J.S. Enhanced photoluminescence properties of Cu-doped ZnO thin films deposited by simultaneous RF and DC magnetron sputtering. Mater. Sci. Semicond. Process. 2016, 49, 8–14. [Google Scholar] [CrossRef]
- Shewale, P.; Yu, Y.S. The effects of pulse repetition rate on the structural, surface morphological and UV photodetection properties of pulsed laser deposited Mg-doped ZnO nanorods. Ceram. Int. 2016, 42, 7125–7134. [Google Scholar] [CrossRef]
- Ansari, M.A.; Alzohairy, M.A. One-Pot Facile Green Synthesis of Silver Nanoparticles Using Seed Extract of Phoenix dactylifera and Their Bactericidal Potential against MRSA. Evidence-Based Complement. Altern. Med. 2018, 2018, 1–9. [Google Scholar] [CrossRef] [PubMed]
- Ali, S.G.; Ansari, M.A.; Khan, H.M.; Jalal, M.; Mahdi, A.A.; Cameotra, S.S. Antibacterial and Antibiofilm Potential of Green Synthesized Silver Nanoparticles against Imipenem Resistant Clinical Isolates of P. aeruginosa. BioNanoScience 2018, 8, 544–553. [Google Scholar] [CrossRef]
- Chen, P.; Sun, J.; Ford, P. Differentiation of the Four Major Species of Cinnamons (C. burmannii, C. verum, C. cassia, and C. loureiroi) Using a Flow Injection Mass Spectrometric (FIMS) Fingerprinting Method. J. Agric. Food Chem. 2014, 62, 2516–2521. [Google Scholar] [CrossRef] [PubMed]
- Suresh, D.; Shobharani, R.M.; Nethravathi, P.C.; Kumar, M.P.; Nagabhushana, H.; Sharma, S.C. Artocarpus gomezianus aided green synthesis of ZnO nanoparticles: Luminescence, photocatalytic and antioxidant properties. Spectrochim. Acta - Part. A Mol. Biomol. Spectrosc. 2015, 141, 128–134. [Google Scholar] [CrossRef] [PubMed]
- Ramesh, M.; Anbuvannan, M.; Viruthagiri, G. Green synthesis of ZnO nanoparticles using Solanum nigrum leaf extract and their antibacterial activity. Spectrochim. Acta Part A Mol. Biomol. Spectrosc. 2015, 136, 864–870. [Google Scholar] [CrossRef]
- Azeredo, C.M.O.; Santos, T.G.; Helena, B.; Noronha, L.D.; Maia, S. In vitro biological evaluation of eight different essential oils against Trypanosoma cruzi, with emphasis on Cinnamomum verum essential oil. BMC Complement. Altern. Med. 2014, 14, 309–317. [Google Scholar] [CrossRef]
- Mathew, S.; Abraham, T.E. Studies on the antioxidant activities of cinnamon (Cinnamomum verum) bark extracts, through various in vitro models. Food Chem. 2006, 94, 520–528. [Google Scholar] [CrossRef]
- Rattanachaikunsopon, P.; Phumkhachorn, P. Potential of cinnamon (Cinnamomum verum) oil to control Streptococcus iniae infection in tilapia (Oreochromis niloticus). Fish. Sci. 2010, 76, 287–293. [Google Scholar] [CrossRef]
- Ahmad, M.; Lim, C.P.; Akowuah, G.A.; Ismail, N.N.; Hashim, M.A.; Hor, S.Y.; Ang, L.F.; Yam, M.F. Safety assessment of standardised methanol extract of Cinnamomum burmannii. Phytomedicine 2013, 20, 1124–1130. [Google Scholar] [CrossRef]
- Kot, B.; Wicha, J.; Piechota, M.; Wolska, K.; Gruzewska, A. Antibiofilm activity of trans-cinnamaldehyde, p-coumaric, and ferulic acids on uropathogenic Escherichia coli. Turk. J. Med. Sci. 2015, 45, 919–924. [Google Scholar] [CrossRef]
- Williams, A.R.; Ramsay, A.; Hansen, T.V.; Ropiak, H.M.; Mejer, H.; Nejsum, P.; Mueller-Harvey, I.; Thamsborg, S.M. Anthelmintic activity of trans - cinnamaldehyde and A- and B-type proanthocyanidins derived from cinnamon (Cinnamomum verum). Sci. Rep. 2015, 5, 14791. [Google Scholar] [CrossRef]
- Zhang, J.-H.; Liu, L.-Q.; He, Y.-L.; Kong, W.-J.; Huang, S.-A. Cytotoxic effect of trans-cinnamaldehyde on human leukemia K562 cells. Acta Pharmacol. Sin. 2010, 31, 861–866. [Google Scholar] [CrossRef]
- Bang, K.; Lee, D.; Park, H.; Rhee, Y. Inhibition of Fungal Cell Wall Synthesizing Enzymes by trans -Cinnamaldehyde. Biosci. Biotechnol. Biochem. 2014, 8451, 1061–1063. [Google Scholar]
- Lakshmeesha, T.R.; Sateesh, M.K.; Prasad, B.D.; Sharma, S.C.; Kavyashree, D.; Chandrasekhar, M.; Bhushana, N. Reactivity of Crystalline ZnO Superstructures against Fungi and Bacterial Pathogens: Synthesized Using Nerium oleander Leaf Extract. Cryst. Growth Des. 2014, 14, 4068–4079. [Google Scholar] [CrossRef]
- CLSI Document M02-A11. Clinical and Laboratory Standards Institute (CLSI). Performance Standards for Antimicrobial Disk Susceptibility Tests, Approved Standard, 7th ed.; CLSI document M02-A11; Clinical and Laboratory Standards Institute: Wayne, PA, USA, 2012. [Google Scholar]
- Clinical and Laboratory Standards Institute (CLSI). Methods for Dilution Antimicrobial Susceptibility Tests for Bacteria that Grow Aerobically, Approved Standard, 9th ed.; CLSI document M07-A9; Clinical and Laboratory Standards Institute: Wayne, PA, USA, 2012. [Google Scholar]
- Chen, X.; Huang, X.; Zheng, C.; Liu, Y.; Xu, T.; Liu, J. Preparation of different sized nano-silver loaded on functionalized graphene oxide with highly effective antibacterial properties. J. Mater. Chem. B 2015, 3, 7020–7029. [Google Scholar] [CrossRef]
- Kumar, N.K.; Murali, M.; Satish, A.; Singh, S.B.; Gowtham, H.G.; Mahesh, H.M.; Lakshmeesha, T.R.; Amruthesh, K.N.; Jagannath, S. Bioactive and biocompatible nature of green synthesized zinc oxide nanoparticles from Simarouba glauca DC.: An endemic plant to western Ghats, India. J. Cluster Sci. 2020, 31, 523–534. [Google Scholar] [CrossRef]
- Anandan, S.; Mahadevamurthy, M.; Ansari, M.A.; Alzohairy, M.A.; Alomary, M.N.; Farha Siraj, S.; HaluguddeNagaraja, S.; Chikkamadaiah, M.; Thimappa Ramachandrappa, L.; Naguvanahalli Krishnappa, H.K.; et al. Biosynthesized ZnO-NPs from Morus indica Attenuates Methylglyoxal-Induced Protein Glycation and RBC Damage: In-Vitro, In-Vivo and Molecular Docking Study. Biomolecules 2019, 9, 882. [Google Scholar] [CrossRef]
- Seshadri, R.; Rao, A.C.N.R.; Muller, A.; Cheetham, A.K. (Eds.) The Chemistry of Nanomaterials; Wiley-VCH Verlag GmbH: Weinheim, Germany, 2004; Volume 1, p. 94. [Google Scholar]
- Sirelkhatim, A.; Mahmud, S.; Seeni, A.; Kaus, N.H.M.; Ann, L.C.; Bakhori, S.K.M.; Hasan, H.; Mohamad, D. Review on zinc oxide nanoparticles: Antibacterial activity and toxicity mechanism. Nano-Micro Lett. 2015, 7, 219–242. [Google Scholar] [CrossRef]
- Baek, Y.-W.; An, Y.-J. Microbial toxicity of metal oxide nanoparticles (CuO, NiO, ZnO, and Sb2O3) to Escherichia coli, Bacillus subtilis, and Streptococcus aureus. Sci. Total. Environ. 2011, 409, 1603–1608. [Google Scholar] [CrossRef]
- Emami-Karvani, Z.; Chehrazi, P. Antibacterial activity of ZnO nanoparticle on gram-positive and gram-negative bacteria. Afr. J. Microbiol. Res. 2011, 12, 1368–1373. [Google Scholar]
- Azam, A.; Ahmed, A.S.; Oves, M.; Khan, M.S.; Habib, S.S.; Memic, A. Antimicrobial activity of metal oxide nanoparticles against Gram-positive and Gram-negative bacteria: A comparative study. Int. J. Nanomed. 2012, 7, 6003–6009. [Google Scholar] [CrossRef] [PubMed]
- Mirhosseini, M.; Firouzabadi, F.B. Antibacterial activity of zinc oxide nanoparticle suspensions on food-borne pathogens. Int. J. Dairy Technol. 2013, 2, 291–295. [Google Scholar] [CrossRef]
- Lindsay, J.A.; Foster, S.J. zur: A Zn2+-responsive regulatory element of Staphylococcus aureus. The GenBank accession number for the sequence reported in this paper is AF101263. Microbiology 2001, 5, 1259–1266. [Google Scholar] [CrossRef] [PubMed]
- Brayner, R.; Ferrari-Iliou, R.; Brivois, N.; Djediat, S.; Benedetti, M.F.; Fievet, F. Toxicological impact studies based on Escherichia coli bacteria in ultrafine ZnO nanoparticles colloidal medium. Nano Lett. 2006, 4, 866–870. [Google Scholar] [CrossRef] [PubMed]
- Outten, C.; O’Halloran, A.T.V. Femtomolar Sensitivity of Metalloregulatory Proteins Controlling Zinc Homeostasis. Science 2001, 292, 2488–2492. [Google Scholar] [CrossRef] [PubMed]
- Reddy, K.M.; Feris, K.; Bell, J.; Wingett, D.G.; Hanley, C.; Punnoose, A. Selective toxicity of zinc oxide nanoparticles to prokaryotic and eukaryotic systems. Appl. Phys. Lett. 2007, 90, 2139021–2139023. [Google Scholar] [CrossRef]
- Mahendra, C.; Murali, M.; Manasa, G.; Ponnamma, P.; Abhilash, M.R.; Lakshmeesha, T.R.; Satish, A.; Amruthesh, K.N.; Sudarshana, M.S. Antibacterial and antimitotic potential of bio-fabricated zinc oxide nanoparticles of Cochlospermum religiosum (L.). Microb. Pathog. 2017, 110, 620–629. [Google Scholar] [CrossRef]
- Padmavathy, N.; Vijayaraghavan, R. Enhanced bioactivity of ZnO nanoparticles-An antimicrobial study. Sci. Technol. Adv. Mat. 2008, 3, 035004. [Google Scholar] [CrossRef]
- Elumalai, K.; Velmurugan, S. Green synthesis, characterization and antimicrobial activities of zinc oxide nanoparticles from the leaf extract of Azadirachta indica (L.). Appl. Surf. Sci. 2015, 345, 329e336. [Google Scholar] [CrossRef]
- Nakkala, J.R.; Mata, R.; Gupta, A.K.; Sadras, S.R. Biological activities of green silver nanoparticles synthesized with Acorous calamus rhizome extract. Eur. J. Med. Chem. 2014, 85, 784–794. [Google Scholar] [CrossRef]
- Hameed, H.; Karthikeyan, C.; Ahamed, A.P.; Thajuddin, N.; Alharbi, N.S.; Alharbi, S.A.; Ravi, G. In vitro antibacterial activity of ZnO and Nd doped ZnO nanoparticles against ESBL producing Escherichia coli and Klebsiella pneumoniae. Sci. Rep. 2016, 6, 24312. [Google Scholar] [CrossRef] [PubMed]
- Ba-Abbad, M.; Takriff, M.S.; Benamor, A.; Mahmoudi, E.; Mohammad, A.W. Arabic gum as green agent for ZnO nanoparticles synthesis: Properties, mechanism and antibacterial activity. J. Mater. Sci. Mater. Electron. 2017, 4, 31–12107. [Google Scholar] [CrossRef]
- Moghaddam, A.B.; Moniri, M.; Azizi, S.; Rahim, R.A.; Bin Ariff, A.; Saad, W.Z.; Namvar, F.; Navaderi, M.; Mohamad, R. Biosynthesis of ZnO Nanoparticles by a New Pichia kudriavzevii Yeast Strain and Evaluation of their Antimicrobial and Antioxidant Activities. Molecules 2017, 22, 872. [Google Scholar] [CrossRef] [PubMed]
- Singh, A.K.; Pal, P.; Tomar, M.; Yadav, T.P.; Gupta, V.; Singh, S.P. Green synthesis, characterization and antimicrobial activity of zinc oxide quantum dots using Eclipta alba. Mater. Chem. Phys. 2018, 203, 40–48. [Google Scholar] [CrossRef]
- Jeyabharathi, S.; Kalishwaralal, K.; Sundar, K.; Muthukumaran, A. Synthesis of zinc oxide nanoparticles (ZnONPs) by aqueous extract of Amaranthus caudatus and evaluation of their toxicity and antimicrobial activity. Mater. Lett. 2017, 209, 295–298. [Google Scholar] [CrossRef]
- Dobrucka, R. Biosynthesis and antibacterial activity of ZnO nanoparticles using Trifolium pratense flower extract. Saudi J. Biol. Sci. 2016, 23, 517–523. [Google Scholar] [CrossRef]
- Supraja, N.; Prasad, T.N.V.K.V.; Dhanesh, A.; Anbumani, D. Synthesis, characterization and evaluation of antimicrobial efficacy and brine shrimp lethality assay of Alstonia scholaris stem bark extract mediated ZnONPs. Biochem. Biophys. Rep. 2018, 14, 69–77. [Google Scholar] [CrossRef]
- Patil, B.N.; Taranath, T.C. Limonia acidissima L. leaf mediated synthesis of zinc oxide nanoparticles: A potent tool against Mycobacterium tuberculosis. Int. J. Mycobacteriol. 2016, 5, 197–204. [Google Scholar] [CrossRef]
- Ali, M.; Kim, B.; Belfield, K.D.; Norman, D.; Brennan, M.; Ali, G.S. Green synthesis and characterization of silver nanoparticles using Artemisia absinthium aqueous extract — A comprehensive study. Mater. Sci. Eng. C 2016, 58, 359–365. [Google Scholar] [CrossRef]
- Suresh, D.; Nethravathi, P.; Udayabhanu; Rajanaika, H.; Bhushana, N.; Sharma, S. Green synthesis of multifunctional zinc oxide (ZnO) nanoparticles using Cassia fistula plant extract and their photodegradative, antioxidant and antibacterial activities. Mater. Sci. Semicond. Process. 2015, 31, 446–454. [Google Scholar] [CrossRef]
- Bhuyan, T.; Mishra, K.; Khanuja, M.; Prasad, R. Biosynthesis of zinc oxide nanoparticles from Azadirachta indica for antibacterial and photocatalytic applications. Mater. Sci. Semicond. Process. 2015, 32, 55–61. [Google Scholar] [CrossRef]
- Ambika, S.; Sundrarajan, M. Plant-extract mediated synthesis of ZnO nanoparticles using Pongamiapinnata and their activity against pathogenic bacteria. Adv. Powder Technol. 2015, 26, 1–6. [Google Scholar]
- Janaki, A.C.; Sailatha, E.; Gunasekaran, S. Synthesis, characteristics and antimicrobial activity of ZnO nanoparticles. Spectrochim. Acta Part A Mol. Biomol. Spectrosc. 2015, 144, 17–22. [Google Scholar] [CrossRef] [PubMed]
- Jalal, M.; Ansari, M.A.; Ali, S.G.; Khan, H.M.; Rehman, S. Anticandidal activity of bioinspired ZnO NPs: Effect on growth, cell morphology and key virulence attributes of Candida species. Artif. Cells Nanomed. Biotechnol. 2018, 46, 912–925. [Google Scholar] [CrossRef] [PubMed]
- Murali, M.; Mahendra, C.; Nagabhushan; Rajashekar, N.; Sudarshana, M.; Raveesha, K.; Amruthesh, K. Antibacterial and antioxidant properties of biosynthesized zinc oxide nanoparticles from Ceropegia candelabrum L. An endemic species. Spectrochim. Acta Part A Mol. Biomol. Spectrosc. 2017, 179, 104–109. [Google Scholar] [CrossRef] [PubMed]
© 2020 by the authors. Licensee MDPI, Basel, Switzerland. This article is an open access article distributed under the terms and conditions of the Creative Commons Attribution (CC BY) license (http://creativecommons.org/licenses/by/4.0/).